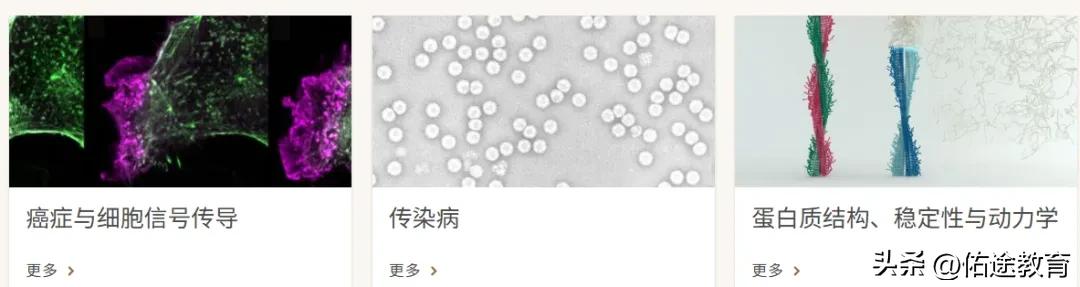

在之前的文章中,小佑分享过英国利兹大学的博士录取,今天要为大家带来的是利兹大学生物科学研究生院的CSC博士提名。
利兹大学

图源网络,侵删
利兹大学(University of Leeds)是一所位于英国利兹市的著名公立研究型大学,在最新发布的2026年QS世界大学排名中位列全球第86位 。
作为英国罗素大学集团创始成员之一,同时也是著名的红砖大学,该校享有卓越的国际声誉 。
利兹大学的历史可追溯至1831年成立的利兹医学院,并于1904年获得皇家宪章正式独立建校 。
如今,它已发展成一所学科设置齐全的综合性大学,其商学院获得“三重认证”,在全球享有盛誉 。
学校的优势学科涵盖工程学、商科、传媒以及食品科学等多个领域 。
依托利兹市的产业优势,利兹大学与劳斯莱斯、BBC、联合利华等世界顶尖企业建立了紧密的合作关系,为学生提供了丰富的实践与科研机会 。
该校学术实力雄厚,培养出6位诺贝尔奖得主,现任英国首相基尔·斯塔默亦是其著名校友 。
生物科学研究生院

利兹大学生物科学研究生院隶属于在科研方面享有盛誉的生物科学学院(Faculty of Biological Sciences)。
该院系凭借其强大的研究实力、多元的学科覆盖以及跨学科的合作文化,在生命科学领域处于领先地位。
学院通过其下辖的生物学院(School of Biology)、生物医学科学学院(School of Biomedical Sciences)和分子与细胞生物学学院(School of Molecular and Cellular Biology),提供一系列优质的本硕博课程。
以核心的MSc Bioscience项目为例,该课程注重前沿研究训练,包含60学分的独立研究项目,并提供生物信息学、先进生物技术、传染病与癌症治疗等广泛的专业选修模块,旨在培养学生扎实的实验室技能与科研能力。
对于希望深入钻研的学生,学院也提供如MSc by Research和PhD等研究型学位,学生将在细胞生物学、植物科学、进化与生态学等优势领域,师从领域专家,开展如基因调控、蛋白质稳态等尖端课题的研究。
这些研究项目常与校内知名的跨学科研究中心(如Astbury中心)联动,应对从可持续农业到人类健康等全球性挑战。
研究领域
上文已知生物科学学院由三个下设学院构成,每个学院有其自己的研究重点。
生物学学院
提供涵盖分子生物学至生态系统的世界级研究,解决一些最紧迫的全球挑战。学院的研究为国家和国际政策提供指导,推动全球可持续发展目标,并支持从地方保护伙伴关系到大规模国际合作的公民参与。
是利兹主要跨学科网络的活跃成员,包括water@leeds和全球食品与环境研究所(GFEI)。学院与非政府组织、行业和政府合作。
研究得到了众多资助方的支持,包括英国研究研究所理事会(BBSRC、NERC、EPSRC)、威康信托和莱弗赫姆信托。
研究领域:

生物医学科学学院
学院研究支撑人类健康与疾病功能的基本生物学和生理学原理。研究分为六个独立的研究小组。
目标是将研究成果转化为临床效益,实现整个生命周期内的最佳人体功能。

分子与细胞生物学学院
该学院的研究和教学由50位学者和独立研究员领导,他们拥有医学研究委员会(MRC)、生物科学研究委员会(BBSRC)、威康信托和英国皇家学会的个人奖学金。学院的多样化的项目以共同目标共同发现健康和疾病中生物功能的机理基础为共同目标。
研究的疾病包括癌症、病毒和细菌感染、蛋白质聚集障碍以及利用病毒、细菌、苍蝇、蠕虫、植物和人体细胞等生物系统进行的血管疾病。我们的研究主要分为三个领域:
课程提供
本科:



授课型硕士:



研究生项目:
提供世界领先的研究团队和实验室的广泛研究生项目(mphil+phd),提供设施、培训和支持。
研究涵盖心血管与运动科学、神经科学与行为学、生物医学技术、作物科学与可持续农业、生态学与保护学、癌症生物学、细胞信号传导、传染病以及蛋白质结构、稳定性与动力学等领域。
有意向的同学可套磁相关领域的博导,申请研究生项目。
提名案例
该同学的CSC奖学金提名于利兹大学的生物科学研究生院,关于该同学的背景可后台滴滴获取更多详情。

CSC申请攻略
根据国家留学基金管理委员会(以下简称国家留学基金委)与英国利兹大学(University of Leeds)签署的合作谅解备忘录,双方每年共同资助中国优秀人员赴该校学习。
2026年资助名额:13人。
选派类别与资助期限:攻读博士学位研究生:中方资助期限不超过48个月。外方资助期限不超过36个月,为保持奖学金生的有效学生身份,在其博士第四年需向大学支付的超时费用将由学生本人承担。
优先选派学科领域:不限。
资助模式:CSC提供相关生活津贴,利兹大学免除学费。
申请截止日期:2026年1月7日
CSC申请程序:
一般先向套磁利兹大学意向领域的博导,得到许可之后再走学校网申程序申请CSC奖学金提名,拿到CSC提名之后,再去CSC官网申请奖学金。